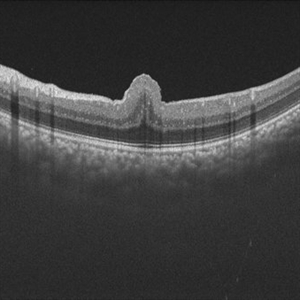
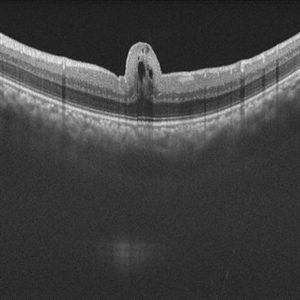
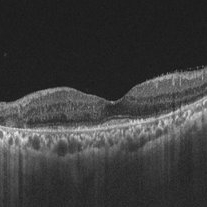

-
 Giant RPE -Rip
Giant RPE -Rip
Sep 5 2021 by Hemanth Murthy, MBBS, MD, FASRS
Fundus photo OD of 50 year-old patient with spontaneous giant RPE rip.
Photographer: Mr Veda Vyas
Imaging device: Heidelberg HRA
Condition/keywords: Giant RPE-Rip, RPE-Rip
-
 Giant RPE rip
Giant RPE rip
Sep 5 2021 by Hemanth Murthy, MBBS, MD, FASRS
Autofluorescence of a 50 year-old patient with spontaneous giant RPE rip.
Photographer: Mr Veda Vyas
Imaging device: Heidelberg HRA
Condition/keywords: RPE-rip
-
 Giant RPE-rip
Giant RPE-rip
Sep 5 2021 by Hemanth Murthy, MBBS, MD, FASRS
Fundus fluorescein angiography of a 50 year-old patient with spontaneous giant RPE rip.
Photographer: Mr Veda Vyas
Imaging device: Heidelberg HRA
Condition/keywords: RPE-Rip
-
 Giant RPE-Rip
Giant RPE-Rip
Sep 5 2021 by Hemanth Murthy, MBBS, MD, FASRS
Fundus fluorescein angiography of a 50 year-old patient with spontaneous giant RPE rip.
Photographer: Mr Veda Vyas
Imaging device: Heidelberg HRA
Condition/keywords: RPE-Rip
-
 Mizuo Nakamura phenomenon
Mizuo Nakamura phenomenon
Apr 16 2022 by Hemanth Murthy, MBBS, MD, FASRS
Oguchi's disease showing the Mizo Nakamura phenomenon in wide field Fundus image
Photographer: Mr Veda Vyas
Imaging device: Optos Daytona
Condition/keywords: congenital stationary night blindness (CSNB)
-
 Mizuo Nakamura phenomenon
Mizuo Nakamura phenomenon
Apr 16 2022 by Hemanth Murthy, MBBS, MD, FASRS
Oguchi's disease showing the Mizo Nakamura phenomenon with autofluorescence image showing normal Fundus
Photographer: Mr Veda Vyas
Imaging device: Optos Daytona
Condition/keywords: congenital stationary night blindness (CSNB)
-
 Mizuo Nakamura phenomenon
Mizuo Nakamura phenomenon
Apr 16 2022 by Hemanth Murthy, MBBS, MD, FASRS
Oguchi's disease showing the Mizo Nakamura phenomenon with autofluorescence image showing normal Fundus
Photographer: Mr Veda Vyas
Imaging device: Optos Daytona
Condition/keywords: congenital stationary night blindness (CSNB)
-
 Choroidal Osteoma
Choroidal Osteoma
Apr 23 2023 by Hemanth Murthy, MBBS, MD, FASRS
This Fundus photograph in red spectrum is of a 16 year girl with bilateral choroidal osteoma with choroidal neovascular membrane
Photographer: Veda Vyas
Imaging device: Optos Daytona
Condition/keywords: choroidal osteoma
-
 Choroidal Osteoma
Choroidal Osteoma
Apr 23 2023 by Hemanth Murthy, MBBS, MD, FASRS
This Fundus photograph in red spectrum is of a 16 year girl with bilateral choroidal osteoma with choroidal neovascular membrane
Photographer: Veda Vyas
Imaging device: Optos Daytona
Condition/keywords: choroidal osteoma
-
 APLA syndrome with Systemic lupus erythematosus retinopathy
APLA syndrome with Systemic lupus erythematosus retinopathy
Jan 14 2024 by Hemanth Murthy, MBBS, MD, FASRS
22 year female presented with loss of vision in right eye since 2 days. Vision was CF. Fundus showed cotton wool patches in posterior pole with large blotchy haemorrhage with fuzzy appearance of arteries and sheathing of veins and dull fovea. OCT showed inner layer hyper reflectivity with SSRD and cystoid edema. APLA was positive and ANA profile positive for SLE
Photographer: Mr Veda Vyas
Imaging device: Optos Daytona
Condition/keywords: APLA Syndrome, systemic lupus erythematosus (SLE) retinopathy
-
 Oculocutaneous Albinism
Oculocutaneous Albinism
Jan 14 2024 by Hemanth Murthy, MBBS, MD, FASRS
9 year boy presented with pendular nystagmus and blurring of vision. He light skin colour with light coloured hair. Fundus picture of right eye
Photographer: Mr Veda Vyas
Imaging device: Optos Daytona
Condition/keywords: albinism
-
 Foveal Hypoplasia
Foveal Hypoplasia
Jan 14 2024 by Hemanth Murthy, MBBS, MD, FASRS
OCT image of right eye showing foveal hypoplasia
Photographer: Mr Veda Vyas
Imaging device: Optos Daytona
Condition/keywords: Albinism
-
 Intriguing Web
Intriguing Web
Aug 28 2024 by Hemanth Murthy, MBBS, MD, FASRS
Right eye of a 43 year female patient came with blurring of vision of right eye since 2 years. There was loose redundant skin in the neck and axilla. Angiod streaks were in a spider web appearance .Vision was 1/60 in right eye and 6/9 in left eye. Right macula showed a sub retinal scar with pigmentation.
Photographer: Mr Veda Vyas
Imaging device: Optos Daytona
Condition/keywords: Angiod streaks in Pseudoxanthoma elasticum
-
 Intriguing Web
Intriguing Web
Aug 28 2024 by Hemanth Murthy, MBBS, MD, FASRS
Left eye of a 43 year female patient came with blurring of vision of right eye since 2 years. There was loose redundant skin in the neck and axilla. Angiod streaks were in a spider web appearance .Vision was 1/60 in right eye and 6/9 in left eye
Photographer: Mr Veda Vyas
Imaging device: Optos Daytona
Condition/keywords: Angiod streaks in Pseudoxanthoma elasticum
-
 Combined Traction Rhegmatogenous Detachment
Combined Traction Rhegmatogenous Detachment
Oct 17 2024 by Hemanth Murthy, MBBS, MD, FASRS
A 68 year old male presented with a shadow in the left eye since 3 days. He was a known diabetic and hypertensive for 20 years. Vision was 20/40 in right eye and 20/60 in left eye. Fundus examination showed Proliferative diabetic retinopathy in right eye and Proliferative diabetic retinopathy with combined traction rhegmatogenous detachment in left eye.
Photographer: Mr Veda Vyas
Condition/keywords: combined retinal detachment, proliferative diabetic retinopathy (PDR)
-
 Vascular Maze-Proliferative Diabetic Retinopathy
Vascular Maze-Proliferative Diabetic Retinopathy
Feb 7 2025 by Hemanth Murthy, MBBS, MD, FASRS
Fundus photo of right eye. A 32 year male with history of blurring of vision in right eye since 4 months. History of Diabetes and Hypertension since 2 years. Vision 6/36 in right eye and 6/9 in left eye
Photographer: Veda Vyas
Condition/keywords: proliferative diabetic retinopathy (PDR)
-
 Vascular Maze-Proliferative Diabetic Retinopathy
Vascular Maze-Proliferative Diabetic Retinopathy
Feb 7 2025 by Hemanth Murthy, MBBS, MD, FASRS
Fundus photo left eye. A 32 year male with history of blurring of vision in right eye since 4 months. History of Diabetes and Hypertension since 2 years. Vision 6/36 in right eye and 6/9 in left eye
Photographer: Veda Vyas
Condition/keywords: proliferative diabetic retinopathy (PDR)
-
 Vascular Maze-Proliferative Diabetic Retinopathy
Vascular Maze-Proliferative Diabetic Retinopathy
Feb 7 2025 by Hemanth Murthy, MBBS, MD, FASRS
OCTA image right eye-A 32 year male with history of blurring of vision in right eye since 4 months. History of Diabetes and Hypertension since 2 years. Vision 6/36 in right eye and 6/9 in left eye
Photographer: Veda Vyas
Condition/keywords: OCT Angiography, proliferative diabetic retinopathy (PDR)
-
 Vascular maze- Proliferative Diabetic Retinopathy
Vascular maze- Proliferative Diabetic Retinopathy
Feb 7 2025 by Hemanth Murthy, MBBS, MD, FASRS
OCTA image left eye. A 32 year male with history of blurring of vision in right eye since 4 months. History of Diabetes and Hypertension since 2 years. Vision 6/36 in right eye and 6/9 in left eye
Photographer: Veda Vyas
Condition/keywords: proliferative diabetic retinopathy (PDR)
-
Retinal Fold in Posterior Microphthalmos
Retinal Fold in Posterior Microphthalmos
Mar 1 2025 by Hemanth Murthy, MBBS, MD, FASRS
Swept source OCT image of Right eye of 34 year male patient with high hypermetropia(+14). BCVA 20/20 in right eye and 20/60 in left eye. Anterior segment was normal. There is loss of foveal pit with omega shaped elevation of inner retinal layers.
Photographer: Mr Veda Vyas
Condition/keywords: posterior microphthalmos
-
 Retinal Fold in Posterior Microphthalmos
Retinal Fold in Posterior Microphthalmos
Mar 1 2025 by Hemanth Murthy, MBBS, MD, FASRS
Fundus photo of Right eye of 34 year male patient with high hypermetropia(+14). BCVA 20/20 in right eye and 20/60 in left eye. Anterior segment was normal. There is loss of foveal pit with omega shaped elevation of inner retinal layers.
Photographer: Mr Veda Vyas
Condition/keywords: posterior microphthalmos
-
 Retinal Fold in Posterior Microphthalmos
Retinal Fold in Posterior Microphthalmos
Mar 1 2025 by Hemanth Murthy, MBBS, MD, FASRS
Fundus photo of left eye of 34 year male patient with high hypermetropia(+14). BCVA 20/20 in right eye and 20/60 in left eye. Anterior segment was normal. There is loss of foveal pit with omega shaped elevation of inner retinal layers.
Photographer: Mr Veda Vyas
Condition/keywords: posterior microphthalmos
-
Retinal Fold in Posterior Microphthalmos
Retinal Fold in Posterior Microphthalmos
Mar 1 2025 by Hemanth Murthy, MBBS, MD, FASRS
Swept source OCT image of left eye of 34 year male patient with high hypermetropia(+14). BCVA 20/20 in right eye and 20/60 in left eye. Anterior segment was normal. There is loss of foveal pit with omega shaped elevation of inner retinal layers.
Photographer: Mr Veda Vyas
Condition/keywords: posterior microphthalmos
-
 White and Red Spots- Roth Spots and Leukemic Infiltrates in Acute Myeloid Leukemia
White and Red Spots- Roth Spots and Leukemic Infiltrates in Acute Myeloid Leukemia
May 11 2025 by Hemanth Murthy, MBBS, MD, FASRS
43 year male patient presented with blurring of vision in right eye since 3 days. Vision 6/12 and left eye vision was 6/6. Haematological workup showed Hemoglobin -10g/dl, WBC count 276440 cells/cu.mm Smear showed large immature myeloid cells.
Photographer: Mr Veda Vyas
Condition/keywords: Acute myeloid leukaemia with Roth spots and leukaemia infiltrates
-
 White and Red Spots- Roth Spots and Leukemic Infiltrates in Acute Myeloid Leukemia
White and Red Spots- Roth Spots and Leukemic Infiltrates in Acute Myeloid Leukemia
May 11 2025 by Hemanth Murthy, MBBS, MD, FASRS
43 year male patient presented with blurring of vision in right eye since 3 days. Vision 6/12 and left eye vision was 6/6. Haematological workup showed Hemoglobin -10g/dl, WBC count 276440 cells/cu.mm Smear showed large immature myeloid cells.
Photographer: Mr Veda Vyas
Condition/keywords: Acute myeloid leukaemia with Roth spots and leukaemia infiltrates
-
 Leukemic Infiltrate
Leukemic Infiltrate
May 11 2025 by Hemanth Murthy, MBBS, MD, FASRS
43 year male patient presented with blurring of vision in right eye since 3 days. Vision 6/12 and left eye vision was 6/6. Haematological workup showed Hemoglobin -10g/dl, WBC count 276440 cells/cu.mm Smear showed large immature myeloid cells.
Photographer: Mr Veda Vyas
Condition/keywords: Acute myeloid leukaemia with Roth spots and leukaemia infiltrates
-
 AZOOR
AZOOR
Sep 25 2025 by Hemanth Murthy, MBBS, MD, FASRS
Autofluorescence image of right eye of a 72 yr male with history of progressive loss of vision and loss of field of vision more in left eye.It shows an area of normal AF, zone of hypoautofluorescence near the disc and a border of stippled hyper fluorescence.
Photographer: Mr Veda Vyas
Condition/keywords: acute zonal occult outer retinopathy (AZOOR)
-
 AZOOR
AZOOR
Sep 25 2025 by Hemanth Murthy, MBBS, MD, FASRS
Ultrawide field Fundus of right eye image of a 72 yr male with history of progressive loss of vision and loos of field of vision more in left eye.
Photographer: Mr Veda Vyas
Condition/keywords: acute zonal occult outer retinopathy (AZOOR)
-
 AZOOR
AZOOR
Sep 25 2025 by Hemanth Murthy, MBBS, MD, FASRS
OCT image of right eye of a 72 yr male with history of progressive loss of vision and loos of field of vision more in right eye. It shows a tribunal pattern of outer retina loss
Photographer: Mr Veda Vyas
Condition/keywords: acute zonal occult outer retinopathy (AZOOR)
-
AZOOR
AZOOR
Sep 25 2025 by Hemanth Murthy, MBBS, MD, FASRS
OCT image of left eye of a 72 yr male with history of progressive loss of vision and loos of field of vision more in left eye. The OCT shows a trizonal pattern of outer retinal loss.
Photographer: Mr Veda Vyas
Condition/keywords: acute zonal occult outer retinopathy (AZOOR)
-
 AZOOR
AZOOR
Sep 25 2025 by Hemanth Murthy, MBBS, MD, FASRS
Ultra wide field Fundus image of the left eye of a 72 yr male with history of progressive loss of vision and loos of field of vision more in left eye.
Photographer: Mr Veda Vyas
Condition/keywords: acute zonal occult outer retinopathy (AZOOR)
-
 AZOOR
AZOOR
Sep 25 2025 by Hemanth Murthy, MBBS, MD, FASRS
Autofluorescence image of a 72 yr male with history of progressive loss of vision and loos of field of vision more in left eye.It shows an area of normal AF, zone of hypoautofluorescence near the disc and a border of stippled hyper fluorescence.
Photographer: Mr Veda Vyas
Condition/keywords: acute zonal occult outer retinopathy (AZOOR)
-
 Pearl in the Eye
Pearl in the Eye
Nov 7 2025 by Hemanth Murthy, MBBS, MD, FASRS
42 year male patient presented with sudden blurring in vision in left eye. His vision was 6/18 (OD) and 1/60 (OS). His IOP was normal with no signs of inflammation. His Fundus revealed healed posterior uveitis in both eyes. This is the image through operating microscope.
Photographer: Mr Vyas
Imaging device: Optos Daytona
Condition/keywords: spontaneous lens dislocation
-
 Pearl in the Eye
Pearl in the Eye
Nov 7 2025 by Hemanth Murthy, MBBS, MD, FASRS
42 year male patient presented with sudden blurring in vision in left eye. His vision was 6/18 (OD) and 1/60 (OS). His IOP was normal with no signs of inflammation. His Fundus revealed healed posterior uveitis in both eyes. This is the image through operating microscope.
Photographer: Mr Vyas
Imaging device: Operating microscope
Condition/keywords: spontaneous lens dislocation

A project from the American Society of Retina Specialists